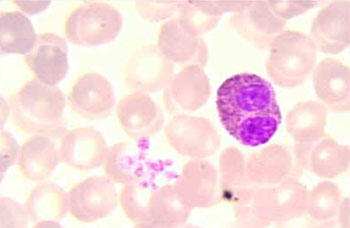

|
Asma
Resposta Tardia da Asma
EOSINÓFILOS
A eosinofilia é um marcador de asma grave e de pacientes em risco de exacerbações mais frequentes |
O eosinófilo é uma célula essencialmente inflamatória, mas que também desempenha um papel importante na homeostase. A infiltração de eosinófilos na parede das vias aéreas e o dano resultante ao epitélio respiratório são características patológicas proeminentes da asma.
Embora os eosinófilos tenham sido descritos há cerca de 145 anos, o crescente interesse por essas células nas últimas três décadas ampliou significativamente o conhecimento sobre seu papel na defesa do hospedeiro e na patogênese de diversas doenças. Devido ao seu envolvimento em condições inflamatórias, tanto alérgicas quanto não alérgicas, os eosinófilos emergiram como um alvo terapêutico promissor.
Os eosinófilos foram observados pela primeira vez por Thomas Wharton Jones em 1846. Paul Ehrlich em 1879 publicou a técnica de coloração de células sanguíneas e seu método de contagem diferencial, utilizando corantes. Mencionava um certo tipo de célula que se corava intensamente pela eosina, um corante sintético vermelho brilhante, acidófilo, produzido pela ação do bromo na fluoresceína, corando as proteínas altamente básicas dos grânulos eosinófilos.
O nome "eosina" foi inspirado na deusa grega Eos, que simboliza o amanhecer, por causa da cor rosada que remete ao nascer do sol. Ehrlich especulou corretamente que o conteúdo dos "alfa-grânulos" eram produtos secretados e descreveu várias causas de eosinofilia, incluindo a asma, várias doenças de pele, helmintíases e reações a medicamentos.1 Os eosinófilos foram observados pela primeira vez por Thomas Wharton Jones em 1846. Paul Ehrlich em 1879 publicou a técnica de coloração de células sanguíneas e seu método de contagem diferencial, utilizando corantes. Mencionava um certo tipo de célula que se corava intensamente pela eosina, um corante sintético vermelho brilhante, acidófilo, produzido pela ação do bromo na fluoresceína, corando as proteínas altamente básicas dos grânulos eosinófilos.
O nome "eosina" foi inspirado na deusa grega Eos, que simboliza o amanhecer, por causa da cor rosada que remete ao nascer do sol. Ehrlich especulou corretamente que o conteúdo dos "alfa-grânulos" eram produtos secretados e descreveu várias causas de eosinofilia, incluindo a asma, várias doenças de pele, helmintíases e reações a medicamentos.1
A eosinofilia sanguínea maior que 4% ou 300–400/µL suporta o diagnóstico de asma, mas a ausência desse achado não é excludente. Contagens de eosinófilos superiores a 8% podem ser observadas em pacientes com dermatite atópica concomitante. Esse achado deve levar em conta também uma pesquisa para pneumonia eosinofílica, aspergilose broncopulmonar alérgica ou síndrome de Churg-Strauss. Os eosinófilos estão presentes por apenas algumas horas no sangue,2 mas podem sobreviver nos tecidos por várias semanas.3
Os eosinófilos são as células efetoras biológicas que geram a inflamação e a hiper-responsividade das vias aéreas em aproximadamente 50% dos pacientes com asma, levando a exacerbações frequentes, comprometimento da função respiratória e redução da qualidade de vida.
A célula numericamente predominante na inflamação inicial e tardia da asma é o eosinófilo (Figura 1). A associação entre eosinófilo e doenças alérgicas já é conhecida há longa data, embora até 1980 acreditava-se que estas células tivessem ação anti-inflamatória. Este falso conceito mudou após o reconhecimento da alta toxicidade das proteínas contidas nos grânulos dos eosinófilos, para os helmintos, células de mamíferos e para as células epiteliais do trato respiratório. Na atualidade os eosinófilos são considerados como células pró-inflamatórias que medeiam as manifestações das doenças alérgicas, incluindo-se a asma.
Os eosinófilos são granulócitos formados na medula óssea, sendo a célula precursora a mesma dos basófilos e já no início de seu desenvolvimento também expressam o antígeno CD34+. Três citocinas, IL-3, IL-5 e GM-CSF, são particularmente importantes na regulação de seu desenvolvimento.4-7 Essas eosinofilopoietinas provavelmente fornecem sinais proliferativos e de diferenciação permissivos seguindo os sinais instrutivos especificados pelos fatores de transcrição GATA-1, PU.1 e c/EBPs.
Dessas três citocinas, a IL-5 é a mais específica da linhagem de eosinófilos e a responsável por sua diferenciação seletiva.8 A IL-5 também estimula a liberação de eosinófilos da medula óssea para a circulação periférica.9 A IL-5 é importante na estimulação da eosinofilopoese; regula a expressão isoforma transmembrana de seu próprio receptor; promove a diferenciação final dos precursores mieloides em eosinófilos e a sua maturação que dura aproximadamente cinco dias (Tabela1).10 Após deixar a medula óssea, os eosinófilos circulam brevemente (meia-vida de 3 a 18 horas) na corrente sanguínea. Eles são então ativados pela IL-5 e por orientação quimiotática pelas eotaxinas em conjunto com IL-4 e IL-13 migram para os tecidos através da diapedese onde liberam o conteúdo dos grânulos citoplasmáticos.
Tabela 1 — Diferenciação do Eosinófilo
Diferenciação Eosinófilo |
Mieloblasto |
➔ |
Promielócito I |
➔ |
Promielócito II |
➔ |
Mielócito |
➔ |
Metamielócito |
➔ |
Eosinófilo Maduro |
| Desenvolvimento |
|
➔ |
|
|
|
➔ |
|
➔ |
|
➔ |
|
Tamanho (mm) |
16 µm |
|
|
|
20 µm |
|
16-18 µm |
|
|
|
16,5 -17 µm |
Os eosinófilos são células tradicionalmente vistas como células pró-inflamatórias participantes ativamente de cascatas inflamatórias inatas e adaptativas, por meio da produção e liberação de diversas quimiocinas, citocinas, mediadores lipídicos e outros fatores de crescimento cujos mRNAs e proteínas já foram totalmente identificados.
No entanto, eles também são cada vez mais reconhecidos como importantes moduladores de vários processos homeostáticos e de imunomodulação. O estudo dos eosinófilos no tubo gastrintestinal é particularmente relevante a esse respeito. Por exemplo, no intestino delgado, que serve como o principal reservatório de eosinófilos, essas células demonstraram influenciar o conteúdo microbiótico e o desenvolvimento do muco e são necessárias para a produção de IgA secretora (SIgA), provavelmente através da produção de IL-1ß.11-13
Foi descrita em estudos em murinos a existência de dois subtipos de eosinófilos: os eosinófilos residentes nos pulmões (rEos) que se desenvolvem independentemente da IL-5, com a função primária de manter a homeostase tecidual e os eosinófilos inflamatórios (iEos), ou eosinófilos recrutados, que se desenvolvem de forma altamente dependente de IL-5 e estão envolvidos principalmente nas respostas imunes.14
As células rEos pulmonares representam um subgrupo de eosinófilos fenotipicamente distinto que participam de respostas imunossupressivas, apresentam núcleo redondo, estão localizados principalmente no parênquima pulmonar,
expressam níveis diferenciais de Siglec-F e CD62L em comparação com eosinófilos inflamatórios e também expressam marcadores de eosinófilos cardinais, incluindo CCR3 e CD123 e são independentes da IL-5, enquanto os eosinófilos que compõem o subtipo iEos apresentam ação pró-inflamatória, são peribrônquicos e dependentes de IL-5, com núcleo segmentado.15
Januskevicius et al. efetuaram testes de provocação em pacientes com asma alérgica utilizando o alérgeno do Dermatophagoides pteronysinnus e observaram um aumento na proporção de iEos que era significativamente maior do que a observada em controles saudáveis (p < 0,05).16
A faixa normal de eosinófilos no sangue periférico é de 0 a 500 células/mm3 constituindo-se em um percentual menor que 5% dos leucócitos totais.17 A contagem absoluta de eosinófilos circulantes no sangue periférico humano varia entre 0,05 e 0,5 × 109/L em condições normais.18
O eosinófilo humano típico apresenta em média de 12 a 17 micrômetros de diâmetro, com um núcleo bilobado, sem nucléolo, ocupado parcialmente por cromatina, mitocôndrias, microtubos, corpúsculos lipídicos (principal depósito de ácido araquidônico), retículo endoplasmático, aparelho de Golgi e grânulos citoplasmáticos intactos. Estes grânulos, três ou quatro tipos, são identificados por microscopia eletrônica:
a) grandes
(0,50,8 µm de diâmetro), densos, esféricos, também chamados de específicos, secundários, ou cristaloides possuem à microscopia eletrônica no núcleo uma estrutura central cristalizada disposta em camadas paralelas, circundadas por matriz mais ou menos eletrodensa. São formados durante o estágio de mielócitos da diferenciação de eosinófilos.19 O núcleo cristalino é constituído pela proteína básica maior (MBP),20-22 enquanto que a matriz granular é constituída pela proteína catiônica eosinofílica (ECP), peroxidase eosinofílica (EPO), proteína X eosinofílica (EPX) e neurotoxina derivada do eosinófilo (EDN).23,24 (Figura 2)  Estas quatro proteínas têm avidez por corantes ácidos como a eosina, advindo daí o nome eosinófilo; Estas quatro proteínas têm avidez por corantes ácidos como a eosina, advindo daí o nome eosinófilo;
b) grânulos maiores sem núcleo, originalmente chamados de grânulos primários, estão presentes em números baixos no citoplasma dos eosinófilos25 e se formam durante o estágio de progranulócitos.26 Constituem uma proteína pertencente à superfamíla das galectinas que forma os chamados cristais bipiramidais de Charcot-Leyden, encontrados no escarro de asmáticos;
c) grânulos pequenos e densos pequenos grânulos;
d) o retículo endoplasmático, o aparelho de Golgi a as mitocôndrias desempenham uma função central na biossíntese de proteínas e de trifosfato de adenosina no eosinófilo;
e) os corpúsculos lipídicos têm importância na produção de eicosanoides, incluindo leucotrienos, prostaglandinas e tromboxane.27Os corpúsculos lipídicos são importantes para a esterificação do ácido araquidônico e produção de eicosanoides em consequência de suas elevadas concentrações de importantes enzimas, tais como a 5-lipoxigenase, ciclooxigenase e leucotrieno C4-sintase.28
Para cada eosinófilo na circulação existem de 100 a 300 eosinófilos nos tecidos. Segundo Lopez et al.29 no conceito atual de subtipos, os autores especulam que p. ex. os iEos representam eosinófilos com migração mediada para sítios de inflamação por IL-5 e pela quimiocina eotaxina, enquanto os rEos podem se distribuir para outros destinos, como pele, mamas, útero e principalmente para o trato gastrintestinal (exceto esôfago) onde os eosinófilos intestinais interagem com o sistema imunológico da mucosa, o epitélio e a microbiota para promover a homeostase.
A fisiopatologia dos eosinófilos na inflamação das vias aéreas depende de interações específicas celulares com o estímulo, citocinas e agentes exógenos. O rápido avanço nos conhecimentos da estrutura celular e da biologia molecular do eosinófilo permite elucidar as várias vias da sinalização transmembrana que transmitem informações de fora para o interior da célula através da interação agonista-receptor. Acredita-se que a participação do eosinófilo na inflamação seja regulada por múltiplos mediadores no próprio local da reação inflamatória. A participação funcional dos eosinófilos pode ser iniciada por interações entre a superfície celular com ligantes particulados e solúveis. A união destes agonistas com os receptores específicos de superfície dos eosinófilos inicia uma cascata de sinais transmembrana que resultam na ativação do eosinófilo, incluindo a exocitose dos grânulos e geração de metabólitos do oxigênio. Como os neutrófilos, os eosinófilos apresentam múltiplas vias de sinalização para sua ativação funcional. Interações ligante-receptor podem ativar as proteínas G, a adenilciclase, o metabolismo fosfolipídico, a fosforilação proteica (serina/treonina ou tirosina), os fluxos [Ca2+], os fatores de transcrição nuclear e as mudanças de pH nos eosinófilos. Múltiplas vias são frequentemente ativadas por uma única interação receptor-ligante.
Os grânulos específicos secundários quando ativados liberam proteínas que são citotóxicas e importantes no mecanismo do dano tecidual. Análises por microscopia eletrônica evidenciam ruptura da membrana plasmática com extravasamento do conteúdo citoplasmático.30-33 A MBP responde por 50% das proteínas dos grânulos secundários. Em baixas doses a MBP causa esfoliação de células epiteliais e distúrbios na função ciliar por perda da ATPase axonemal e mudanças na secreção de água e cloretos.30 Em altas concentrações, tem alta capacidade destrutiva do epitélio expondo a camada basal. Através da técnica de imunofluorescência constata-se a deposição de MBP nos locais de dano epitelial.32 A MBP causa contração da musculatura lisa peribrônquica, aumenta a hiper-responsividade brônquica e reduz a atividade e frequência dos batimentos ciliares. Existem evidências de que seletivamente bloqueie os receptores colinérgicos subtipo M2 nas terminações nervosas das vias aéreas, diminuindo a liberação de acetilcolina. A MBP através deste bloqueio pode aumentar a broncoconstrição mediada pelo vago, contribuindo para aumentar ainda a sensibilidade colinérgica na asma.34 A MBP pode estimular a liberação de histamina e leucotrieno C4 de basófilos humanos e pode ativar mastócitos. Além disso, DNA e RNA são encontrados em grânulos secundários,35 sugerindo que a síntese de proteínas também possa ocorrer dentro dos grânulos eosinofílicos.
A ECP tem ação semelhante à MBP, enquanto que a EPO, em baixas concentrações, causa cilioestase e esfoliação epitelial. A ECP demonstrou ser 8 a 10 vezes mais potente do que MBP.36 Estudos têm demonstrado que MBP, ECP e EPO induzem a uma estimulação não citolítica da histamina tanto em basófilos como em mastócitos. Como dado adicional é mencionada a atividade ribonuclease que têm ECP e EDN.37,38

Frequentemente os cristais de Charcot-Leyden são encontrados incorporados em acúmulos de muco nas vias aéreas superiores e inferiores39 (Figura 3). Identificados inicialmente por Jean-Martin Charcot40 e Ernst Viktor von Leyden,41 os CCLs estão associados à asma persistente, desempenhando um papel significativo na indução da inflamação nas vias aéreas. Além disso, esses cristais estão implicados na ocorrência de
metaplasia das células caliciformes, hiper-responsividade e na síntese exacerbada de IgE.39 Destaca-se que os CCLs estimulam as respostas imunes do Tipo Th2, enquanto uma forma mutante solúvel é considerada inerte.39 Essas descobertas evidenciam a complexidade e a multifuncionalidade dos CCLs no contexto das condições inflamatórias das vias respiratórias.
A detecção dos CCLs nas vias aéreas pode desencadear a ativação contínua de células imunológicas e células epiteliais, estabelecendo um ciclo alimentador que culmina na obstrução das vias aéreas e na instauração de um quadro crônico de inflamação do Tipo 2.42 É importante destacar que, diferentemente de outras proteínas granulares, a liberação de CCL não ocorre por desgranulação fragmentada ou exocitose composta, mas sim após a ruptura da membrana plasmática durante a citólise dos eosinófilos.43
Os eosinófilos produzem uma grande quantidade de LTC4 e uma pequena de LTB4, ao contrário dos neutrófilos, que produzem grandes quantidades de LTB4 e pequenas quantidades de LTC4. Várias enzimas que participam do metabolismo do ácido araquidônico estão localizadas nos chamados corpúsculos lipídicos, encontrados no citoplasma de eosinófilos ativados. Os LTs na asma participam na contração da musculatura lisa brônquica, promovem a produção de muco, a descamação do epitélio brônquico e a redução do transporte mucociliar, alteram a permeabilidade microvascular favorecendo o edema e a inflamação eosinofílica, aumentam a expressão de moléculas de adesão no endotélio vascular, favorecendo a marginação leucocitária e causam quimiotaxia específica (LTD4) para os eosinófilos.
Os eosinófilos humanos secretam inúmeras citocinas, sendo que IL-4, IL-5, IL-13, TNF-α, TGF-β e GM-CSF são aquelas que desempenham papel central na inflamação associada à asma. Promovem o recrutamento de células inflamatórias, o remodelamento das vias aéreas e a hiper-responsividade brônquica.
As mais diversas funções dos eosinófilos são retratadas em seu amplo conjunto de moléculas de superfície e receptores que integram os eosinófilos com o sistema imune inato e adaptativo.47
O receptor considerado mais importante é o heterodimérico para IL-5, sendo a sua subunidade beta idêntica à subunidade beta dos receptores do GM-CSF e da IL-3 (ambos também presentes nas membranas das células eosinófilas). A subunidade a, IL-5Ra, é específica para IL-5 e foi identificada como um alvo terapêutico para asma eosinofílica grave e outras condições mediadas por eosinófilos. Os eosinófilos expressam receptores para IL-4, IL-13, IL-33, para o fator de crescimento transformador-ß (TGF-ß) e linfopoietina estromal tímica (TSLP).47
Os eosinófilos podem ampliar a cascata inflamatória produzindo agentes quimiotáxicos, como CCL5 (RANTES), CCL11 (eotaxina-1), CCL24 (eotaxina-2), CCL26 (eotaxina-3), CCL13 (MCP-4) e o fator de ativação plaquetaria (PAF), que aceleram a mobilização de novos eosinófilos e seus precursores para a circulação.46-50 Os níveis de RANTES, um produto das células T ativadas, encontram-se elevados nas vias aéreas de asmáticos atópicos e não atópicos, promovendo a infiltração de eosinófilos e células T.51 A expressão da RANTES tem sido localizada no músculo liso brônquico, nos eosinófilos e células T da submucosa. CCR1 é um receptor-chave de quimiocina nos eosinófilos, o qual é ativado pelo ligante de citocina 3 (CCL-3) e CCL-5. A eotaxina, uma quimiocina da família CC, é descrita como um agente quimiotáxico específico para eosinófilos.52 Após provocação alergênica, a expressão da eotaxina correlaciona-se com o número total de eosinófilos e de eosinófilos ativados, bem como com o nível de obstrução das vias aéreas de pacientes com asma. A CCL13 (MCP-4) é outra quimiocina que tem sido identificada nas vias aéreas, atuando em paralelo com a eotaxina em termos de recrutamento de eosinófilos.53 O receptor 3 da quimiocina CC (CCR3) é um importante receptor acoplado à proteína G nas membranas celulares dos eosinófilos e se liga a quimiocinas como MCP-3 e MCP-4. Os eosinófilos mantêm altos níveis de éter fosfolipídico (a forma estocada precursora do PAF) e produzem o PAF através da acetilação utilizando a enzima 1-alcalil-liso-sn-glicero-3 fosfocolina:acetil-CoAacetiltransferase. Os eosinófilos possuem receptores de superfície celular para mediadores lipídicos, como leucotrienos, prostaglandinas e PAF, todos os quais demonstraram ter um papel na fisiopatologia da asma.54-56 O PAF é um dos mais potentes agentes seletivos de quimiotaxia para os eosinófilos,57 sendo mais potente que a histamina e o LTB4. Quando liberado por eosinófilos no sítio da inflamação o PAF pode coestimular a quimiotaxia para eosinófilos e causar a liberação da enzima peroxidase eosinofílica (EPO).58 O Interferon-gama (IFN- γ), uma citocina Tipo 1 secretada por eosinófilos, também pode ativá-los,59 e se encontra elevado no soro de alguns pacientes asmáticos graves,60 ressaltando a importância dessas vias na asma severa.
Os eosinófilos, juntamente com outras células estruturais e imunológicas, são uma fonte abundante de óxido nítrico sintase induzível (iNOS).61 Pela oxidação da L-arginina em L-citrulina, a iNOS sintetiza óxido nítrico (NO), uma importante molécula de sinalização, neurotransmissor e regulador imunológico e de defesa do hospedeiro.62 Altos níveis de NO derivado da iNOS estão fortemente associados à inflamação Tipo 2 (T2)-alta das vias aéreas na asma. Consequentemente, a fração exalada de NO (> 20–25 ppb) na respiração de pacientes com asma, juntamente com a eosinofilia do sangue periférico (150–300 µ/L), é usada como um biomarcador preditivo não invasivo, identificando aqueles pacientes que se beneficiarão de tratamento com drogas anti-inflamatórias, como os corticoides por inalação,63 e no curso da doença na eventualidade do fenótipo da asma grave, indicar tratamento com biológicos.
In vitro diversas substâncias têm sido capazes de prolongar a sobrevida dos eosinófilos (antagonizam a apoptose) e estimular a degranulação, dentre elas a IL-3, IL-5, GM-CSF e complexos de imunoglobulinas. Recrutados na circulação, os eosinófilos maduros na presença de citocinas (IL-3, IL-5 e GM-CSF) mudam seu fenótipo para eosinófilos, os quais apresentam maior tempo de sobrevida no tecido brônquico, retardando a apoptose por 7 a 14 dias.64-66 Estudos através de lavado broncoalveolar em pacientes com asma sintomáticos, apontam o GM-CSF como a citocina mais importante na sobrevida do eosinófilo, retardando a apoptose. Acredita-se que o GM-CSF seja sintetizado predominantemente pelo epitélio brônquico,67 ao nível da membrana basal, penetrando na luz brônquica mais facilmente que a IL-5, que é sintetizada na lâmina própria, abaixo da membrana basal. A IL-5 pode ter influência na sobrevida do eosinófilo principalmente na lâmina própria, enquanto que o GM-CSF atuaria no epitélio e luz brônquicos. O GM-CSF ativado do macrófago alveolar, obtido de pacientes com asma, é capaz de aumentar a fagocitose e a produção pelos eosinófilos de LTC4, de superóxidos, a atividade citotóxica e a degranulação induzida por imunoglobulinas.68,69 Os eosinófilos participam ainda das alterações estruturais crônicas das vias aéreas (remodelamento), possivelmente através da elaboração de citocinas pró-fibróticas como TGF-ß70 e MMP-9.71 O TGF-ß está implicado no remodelamento por meio da proliferação de fibroblastos e aumento da produção de colágeno e glicosaminoglicanos.72,73
Nas últimas décadas novas citocinas foram identificadas nos eosinófilos, como a IL-9, a IL-11 e o leukaemia inhibitory factor (LIF) e o já citado interferon-g.74 A IL-9 tem sido implicada como um componente importante nas doenças atópicas, pela sua capacidade de estimular a proliferação de células T, a produção de IgE e a proliferação e diferenciação de células hematopoéticas primitivas precursoras.75,76 A expressão da IL-11 mRNA em eosinófilos foi obtida em biópsias brônquicas de asmáticos atópicos e sugere um papel dos eosinófilos no remodelamento das vias aéreas.65 Tanto os eosinófilos de asmáticos atópicos como os de não atópicos expressam o LIF que, similarmente ao nerve growth factor (NGF), é capaz de induzir a liberação da EPO.77 A descrição da síntese de IFN-g mRNA e proteína pelos eosinófilos é até certo ponto intrigante e controverso, pois os eosinófilos secretam predominantemente citocinas Tipo Th2.78 Estes autores propõem que os eosinófilos, como as células T, podem expressar citocinas Tipo Th1 e Th2, embora outros pesquisadores tenham tido dificuldades em reproduzir estes resultados. Estes achados requerem novas investigações experimentais para confirmar a expressão de citocinas do Tipo Th1 pelos eosinófilos e a potencial participação no contexto da inflamação alérgica. Outros mediadores dos eosinófilos importantes na patogênese da asma incluem a substância P (SP), peptídio relacionado ao gene da calcitonina (CGRP) e neurocinina A (NkA).79
Os eosinófilos também expressam receptores para múltiplas outras citocinas e fatores de crescimento, inclusive para IL-4, IL-13, IL-33, linfopoetina estromal tímica (TSLP) e fator de crescimento transformador-ß (TGF-ß). (Figura 4)

Figura 4 — Representação gráfica mostrando moléculas de superfície expressas por eosinófilos humanos. Retirado com modificações de Wiley online library. Hogan SP et al. Clin Exp Allergy. 2008 May;38(5):709-50.
Os receptores de adesão, como o próprio nome sugere, permitem que células, como o eosinófilo, adiram à matriz extracelular (MEC) e a outras células. Eles também permitem que o eosinófilo perceba seu entorno e responda de acordo. Os receptores de adesão são divididos em quatro grupos principais: integrinas, caderinas, selectinas e immunoglobulin-like cell adhesion molecules (Ig-CAM). Integrinas e selectinas são as principais formas de receptores de adesão expressas em membranas celulares eosinofílicas.
Os eosinófilos expressam sete tipos de integrinas, que são glicoproteínas transmembrana, consistindo de uma cadeia a e ß.80 Os exemplos incluem very late antigen-4 (VLA-4, CD49d / CD29) e o complement receptor CR3 (CD11b / CD18), que é também conhecido como macrophage-1 antigen (Mac-1), alphaLbeta2 (CD11a/18), alphaXbeta2 (CD11c/18), alphaDbeta2 (CD11d /18) e alpha4beta7 (CD49d/beta7).81
As selectinas são glicoproteínas transmembranas de cadeia única com múltiplos domínios. Existem três famílias: E-, L- e P-selectinas; os dois últimos são expressos por eosinófilos humanos, enquanto que a E-selectina está presente no endotélio ativado.82
A IL-25 provoca um tipo de inflamação Th2-skewed marcada por superexpressão das citocinas IL-4, IL-5 e IL-13, observando-se que em pacientes com asma isso leva a um aumento nos níveis séricos de IgE, eosinofilia sanguínea e alterações patológicas nos pulmões caracterizadas por aumento de produção de muco e hiperplasia de células epiteliais.83,84 A liberação de IL-25 pelas células epiteliais das vias aéreas contribui para muitas outras características patogênicas da asma, incluindo o recrutamento de eosinófilos e remodelação das vias aéreas. A ativação de eosinófilos pela IL-25 aumenta a expressão gênica e a liberação de várias quimiocinas, incluindo monocyte chemotactic protein-1 (MCP-1), proteína inflamatória do macrófago-1a (MIP-1a) e citocinas IL-8 e IL-6.85 Além disso, IL-25 demonstrou aumentar significativamente a expressão de superfície da molécula de adesão intercelular-1 (ICAM-1) enquanto suprime ICAM-3 e L-selectina em eosinófilos, facilitando assim transmigração endotelial.86
A relação entre os eosinófilos e a IL-33 é complexa, pois a IL-33 pode influenciar o recrutamento de eosinófilos, especialmente no contexto da asma. Após o dano do epitélio a IL-33 pode orquestrar o recrutamento e ativação de células responsáveis pela inflamação. A expressão de IL-33 é regulada positivamente na mucosa brônquica de pacientes asmáticos, relacionada à gravidade da doença.87,88 Nos brônquios, a liberação de IL-33 foi proposta como responsável pelo desencadeamento e exacerbação da hipersensibilidade das vias aéreas e asma.89,90
Quando há dano tecidual ou inflamação, as células da área afetada liberam IL-33. A IL-33 então se liga ao seu receptor, conhecido como ST2, que está presente na superfície de várias células imunes, incluindo eosinófilos. Essa ligação ativa os eosinófilos, levando à liberação de moléculas pró-inflamatórias e citocinas. Evidências apontam que os eosinófilos são regulados pela IL-33 nos mecanismos de resposta inflamatória alérgica. A IL-33 pode ativar eosinófilos humanos in vitro.91-93 Após sua ligação aos receptores nos eosinófilos, as vias NF-kB e MAPK (mitogen-activated protein kinase) são ativadas,92 promovendo a expressão na superfície celular da ß2-integrina CD11b e molécula de adesão celular intercelular-1 (ICAM-1) e produção das citocinas pró-inflamatórias IL-6, IL-8 e IL-13.91
A IL-33 induz eosinofilia sustentada in vivo,94-96 e a diferenciação de eosinófilos das células precursoras da medula óssea CD117+ de maneira dependente de IL-5 e independente de IL-13. Segundo Stolarski et al. a IL-33 é capaz de induzir a expansão de uma subpopulação de progenitores de granulócitos / monócitos CD117+ que foram caracterizados por sua dependência da IL-5.97,98 No entanto, não está claro se isso é alcançado de maneira direta ou indireta.
|
|
Home
 Design by Walter Serralheiro Design by Walter Serralheiro
|
|
Referências
01.Kay AB. The early history of The eosinophil. Clin Exp Allergy. 2015;45:575-582.
02.Valent P, Gleich GJ, Reiter A, Roufosse F, Weller PF, Hellmann A, et al. PaThogenesis and classification of eosinophil disorders: a review of recent developments in The field. Expert Rev Hematol 2012;5:15776.
03.Carlens J, Wahl B, Ballmaier M, Bulfone-Paus S, Förster R, Pabst O. Common gamma-chain-dependent signals confer selective survival of eosinophils in The murine small intestine. J Immunol 2009;183:56007.
04.Lopez AF, Begley CG, Williamson DJ, Warren DJ, Vadas MA, Sanderson CJ. Murine eosinophil differentiation factor. An eosinophil-specific colony-stimulating factor wiTh activity for human cells. J Exp Med 1986; 163:1085-99.
05.Lopez AF, Sanderson CJ, Gamble JR, Campbell HD, Young IG, Vadas MA. Recombinant human interleukin 5 is a selective activator of human eosinophil function. J Exp Med 1988; 167:219-24.
06.RoThenberg ME. Eosinophilia. N Engl J Med 1998; 338:1592-600.
07.Takatsu K, Takaki S, Hitoshi Y. Interleukin-5 and its receptor system: implications in The immune system and inflammation. Adv Immunol 1994; 57:145-90.
08.Sanderson CJ. Interleukin-5, eosinophils, and disease. Blood 1992; 79:3101-9.
09.Collins PD, Marleau S, GriffiThs-Johnson DA, Jose PJ, Williams TJ. Cooperation between interleukin-5 and The chemokine eotaxin to induce eosinophil accumulation in vivo. J Exp Med 1995; 182:1169-74.
10.Kroegel C, Virchow JC, Luttmann W, Walker C, , Warner JA. Pulmonary immune cells in healTh and disease: The eosinophil leucocyte (part I). Eur Respir J 1994;7:519-43.
11.Jung Y, Wen T, Mingler MK, Caldwell JM, Wang YH, Chaplin DD, Lee EH, Jang MH, Woo SY, Seoh JY, Miyasaka M, RoThenberg ME. IL-1ß in eosinophil-mediated small intestinal homeostasis and IgA production. Mucosal Immunol 2015; 8:930-42.
12.Chu VT, et al. Eosinophils promote Generation and maintenance of immunoglobulin-A-expressing plasma cells and contribute to gut imune homeostasis. Immunity 2014; 40:582593.
13.Wechsler ME, Munitz A, Ackerman SJ, Drake MG, Jackson DJ, Wardlaw AJ, Dougan SK, Berdnikovs S, Schleich F, Matucci A, Chanez P, Prazma CM, HowarTh P, Weller PF, Merkel PA. Eosinophils in HealTh and Disease: A State-of-The-Art Review. Mayo Clin Proc 2021; 96:2694-2707.
14.Mesnil C., Raulier S., Paulissen G., Xiao X., Birrell M.A., Pirottin D., Janss T., Starkl P., Ramery E., Henket M. Lung-resident eosinophils represent a distinct regulatory eosinophil subset. J. Clin. Investig 2016; 126:32793295.
15.RoThenberg ME. A hidden residential cell in The lung. J Clin Invest 2016; 126:3185-7.
16.Januskevicius A, Jurkeviciute E, Janulaityte I, Kalinauskaite-Zukauske V, Miliauskas S, Malakauskas K. Blood Eosinophils Subtypes and Their Survivability in AsThma Patients. Cells. 2020; 9:1248.
17.Kuang FL. Approach to Patients wiTh Eosinophilia. Med Clin NorTh Am 2020; 104:1-14.
18.Valent P, Klion AD, Horny HP, Roufosse F, Gotlib J, Weller PF, Hellmann A, MetzgeroTh G, Leiferman KM, Arock M, Butterfield JH, Sperr WR, Sotlar K, Vandenberghe P, Haferlach T, Simon HU, Reiter A, Gleich GJ. Contemporary consensus proposal on criteria and classification of eosinophilic disorders and related syndromes. J Allergy Clin Immunol 2012; 130:607-612.e9.
19.Bainton DF, Farquhar MG. Segregation and packaging of granule enzymes in eosinophilic leukocytes. J Cell Biol 1970; 45: 54-73.
20.Hogan SP, Rosenberg HF, Moqbel R, Phipps S, Foster PS, Lacy P, Kay AB, RoThenberg ME. Eosinophils: biological properties and role in healTh and disease. Clin Exp Allergy 2008; 38:709-50.
21.Lewis DM, Lewis JC, Loegering DA, Gleich GJ. Localization of The guinea pig eosinophil major basic protein to The core of The granule. J Cell Biol 1978; 77:702-13.
22.Gleich GJ, Loegering DA, Maldonado JE. Identification of a major basic protein in guinea pig eosinophil granules. J Exp Med 1973; 137:1459-71.
23.Egesten A, Alumets J, von Mecklenburg C, Palmegren M, Olsson I. Localization of eosinophil cationic protein, major basic protein, and eosinophil peroxidase in human eosinophils by immunoelectron microscopic technique. J Histochem Cytochem 1986; 34:1399-403.
24.Peters MS, Rodriguez M, Gleich GJ. Localization of human eosinophil granule major basic protein, eosinophil cationic protein, and eosinophil-derived neurotoxin by immunoelectron microscopy. Lab Invest 1986; 54:656-62.
25.Melo RCN, Weller PF. Contemporary understanding of The secretory granules in human eosinophils. J Leukoc Biol 2018; 104:85-93.
26.Bainton DF, Farquhar MG. Segregation and packaging of granule enzymes in eosinophilic leukocytes. J Cell Biol 1970; 45:54-73.
27.Rosenberg HF, Dyer KD, Foster PS. Eosinophils: changing perspectives in healTh and disease. Nat Rev Immunol 2013;13:922.
28.Shamri R, Xenakis JJ, Spencer LA. Eosinophils in innate immunity: an evolving story. Cell Tissue Res 2011;343:5783.
29.Cabrera López C, Sánchez Santos A, Lemes Castellano A, Cazorla Rivero S, Breña Atienza J, González Dávila E, Celli B, Casanova Macario C. Eosinophil Subtypes in Adults wiTh AsThma and Adults wiTh Chronic Obstructive Pulmonary Disease. Am J Respir Crit Care Med 2023; 208:155-162.
30.Kroegel C, Warner JA, Virchow JC, MatThys H. Pulmonary immune cells in healTh and disease: The eosinophil leucocyte (part II). Eur Respir J 1994; 7:743-60.
31.Gleich GJ, Frigas E, Loegering DA, Wasson DI, Steinmuller D. Cytotoxic properties of The eosinophil major basic protein. J Immunol 1979; 123:2925-7.
32.Gleich GJ. The role of The eosinophil. Bull Eur PhysiopaThol Resp 1986; 22:62-9.
33.Naylor B. The shedding of The mucosa of The bronchial tree in asThma. Thorax 1962;17:69-72.
34.Nakamura Y, Ghaffar O, Olivenstein R et al. Gene expression of The GATA-3 transcription factor is increased in atopic asThma. J Allergy Clin Immunol 1999; 103:215-22.
35.Behzad AR, Walker DC, Abraham T, McDonough J, Mahmudi-Azer S, Chu F, Shaheen F, Hogg JC, Paré PD. Localization of DNA and RNA in eosinophil secretory granules. Int Arch Allergy Immunol 2010; 152:12-27.
36.Ackerman SJ, Gleich GJ, Loegering DA, Richardson BA, ButterworTh AE. Comparative toxicity of purified human eosinophil granule cationic proteins for schistosomula of Schistosoma mansoni. Am J Trop Med Hyg 1985; 34:73545.
37.Slifman NR, Loegering DA, McKean DJ, Gleich GJ. Ribonuclease activity associated wiTh human eosinophil-derived neurotoxin and eosinophil cationic protein. J Immunol 1986;137:2913.
38.Gleich GJ, Loegering DA, Bell MP, Checkel JL, Ackerman SJ, McKean DJ. Biochimical and functional similarities between human eosionophil-derived neurotoxin and eosinophil cationic protein: homology and ribonuclease. Proc Natl Acad Sci USA 1986; 83:3146.
39. Persson EK, Verstraete K, Heyndrickx I, Gevaert E, Aegerter H, Percier JM, Deswarte K, Verschueren KHG, Dansercoer A, Gras D, Chanez P, Bachert C, Gonçalves A, Van Gorp H, De Haard H, Blanchetot C, Saunders M, Hammad H, Savvides SN, Lambrecht BN. Protein crystallization promotes type 2 immunity and is reversible by antibody treatment. Science 2019; 364(6442):eaaw4295.
40.Charcot JM, Robin C. Observation de leucocyThemie. Mem. Soc. Biol 1853; 5:4450.
41.Leyden E. Zur Kenntniss des Bronchial-AsThma. Arch PaThol Anat Physiol Klin Med 1872; 54:32444.
42.Aegerter H, Lambrecht BN. The PaThology of AsThma: What Is Obstructing Our View? Annu Rev PaThol 2023; 18:387-409.
43.Melo RCN, Wang H, Silva TP, Imoto Y, Fujieda S, Fukuchi M, Miyabe Y, Hirokawa M, Ueki S, Weller PF. Galectin-10, The protein That forms Charcot-Leyden crystals, is not stored in granules but resides in The peripheral cytoplasm of human eosinophils. J Leukoc Biol 2020; 108:139-149.
44.Luna-Gomes T, Bozza PT, Bandeira-Melo C. Eosinophil recruitment and activation: The role of lipid mediators. Front Pharmacol 2013; 4:27.
45.Lam BK, Owen WF JR, Austen KF, Soberman RJ. The identification of a distinct export step following The biosynThesis of leukotriene C4 by human eosinophils. J Biol Chem 1989;264:12885-9.
46.Loe DW, Almquist KC, Deeley RG, Cole SPC. Multidrug resistance protein (MRP)-mediated transport of leukotriene C4 and chemoTherapeutic agents in membrane vesicles: demonstration of gluThation of gluThaThione-dependent vincristine transport. J Biol Chem 1996;271:9675-82.
47.McBrien CN, Menzies-Gow A. The Biology of eosinophils and Their role in asThma. Front. Med 2017; 4:93. doi: 10.3389/fmed.2017.00093.
48.RoThenberg ME, Hogan SP. The eosinophil. Annu Rev Immunol 2006;147:24:147-74.
49.Kariyawasam HH, Robinson DS. The eosinophil: The cell and its weapons, The cytokines, The locations. Semin Respir Crit Care Med 2006;27:117-27.
50.Yousefi S, Hemmann S, Weber M, Hölzer C, Hartung K, et al. IL-8 is expressed by human peripheral blood eosinophils. Evidence for increased secretion in asThma. J Immunol 1995; 154:5481-90.
51.Berkman N, Krishnan VL, Gilbey T et al. Expression of RANTES mRNA and protein in airways of patients wiTh mild asThma. Am J Respir Crit Care 1996; 154:1804:1811.
52.Ying S, Robinson DS, Meng Q, Rottman J, et al. Enhanced expression of eotaxin and CCR3 mRNA and protein in atopic asThma. Association wiTh airway hyperresponsiveness and predominat co-localization of eotaxin mRNA to bronchial epiThelial and endoThelial cells. Eur J Immunol 1997; 17:3507-16.
53.Uguccioni M, Loetscher P, Dewald B, et al. Monocyte chemotactic protein 4 (MCP-4), a novel structural and functional analogue of MCP-3 and eotaxin. J Exp Med 1996; 183:2379-84.
54.Singh RK, Tandon R, Dastidar SG, Ray A. A review on leukotrienes and Their receptors wiTh reference to asThma. J AsThma 2013; 50:9:92231.
55.Bisgaard H. Leukotrienes and prostaglandins in asThma. Allergy 1984; 39:41320.
56.Palgan K, Bartuzi Z. Platelet activating factor in allergies. Int J ImmunopaThol Pharmacol 2015; 28:5849.
57.Chung KF. Platelet-activating factor in inflammation and pulmonary disorders. Clin Sci 1992; 83:127-138.
58.Kroegel C, Yukawa T, Dent G, Chung KF, Barnes PJ. Platelet activating factor induces eosinophil peroxidase release from human eosinophils. Immunology 1988; 64:559-562.
59.Valerius T, Repp R, Kalden JR, Platzer E. Effects of IFN on human eosinophils in comparison wiTh oTher cytokines. A novel class of eosinophil activators wiTh delayed onset of action. J Immunol 1990;145:29508.
60.Corrigan CJ, Kay AB. CD4 T-lymphocyte activation in acute severe asThma. Relationship to disease severity and atopic status. Am Rev Respir Dis 1990;141(4 Pt 1):9707.
61.Yancey SW, Keene ON, Albers FC, Ortega H, Bates S, Bleecker ER, et al. Biomarkers for severe eosinophilic asThma. J Allergy Clin Immunol 2017;140:150918.
62.Cinelli MA, Do HT, Miley GP, Silverman RB. Inducible nitric oxide synThase: Regulation, structure, and inhibition. Med Res Rev 2020;40:158-189.
63.Diamant Z, Vijverberg S, Alving K, Bakirtas A, Bjermer L, Custovic A, et al. Toward clinically applicable biomarkers for asThma: an EAACI position paper. Allergy 2019;74:183551.
64.RoThenberg ME, Owen WF Jr, Silberstein DS, Woods J, Soberman RJ, Austen KF, Stevens RL. Human eosinophils have prolonged survival, enhanced functional properties, and become hypodense when exposed to human interleukin 3. J Clin Invest 1988; 81:1986-9.
65.Owen WF, RoThenberg ME, Silberstein DS, et al. Regulation of human eosinophil viability, density and function by granulocyte/macrophage colony-stimulating factor in The presence of 3T3 fibroblasts. J Exp Med 1987; 166:129.
66.Simon HU, Yousef S, Schranz C, Schapowal A, Bachert C, Blaser K. Direct demonstration of delayed eosinophil apoptosis is a mechanism causing tissue eosinophilia. J Immunol 1997; 58:3902-8.
67.Sousa AR, Poston RN, Lane SJ, Nakhosteen JA, Lee TK. Detection of GM-CSF in asThmatic bronchial epiThelium and decrease by inhaled corticosteroids. Am Rev Respir Dis 1993; 147:1557-61.
68.Silberstein DS, Owen WF, Gasson JC, DiPersio JF, Golde DW, Bina JC, Soberman R, Austen KF, David JR. Enhancement of human eosinophil cytotoxicity and leukotriene synThesis by biosynThetic (recombinant) pneumocyte-macrophage colony-stimulating factor. J Immunol 1986; 137:3290-4.
69.Howell CJ, Pujol JL, Crea AE, Davidson R, Gearing AJ, Godard P, Lee Th. Identification of an alveolar macrophage-derived activity in bronchial asThma That enhances leukotriene C 4 generation by human eosinophils stimulated by A23187 as a granulocyte-macrophage colony-stimulating factor. Am Rev Respir Dis 1989; 140:1340-7.
70. Minshall EM, Leung DY, Martin RJ, Song YL, Cameron L, Ernst P, Hamid Q. Eosinophil-associated TGF-ß mRNA expression and airways fibrosis in bronchial asThma. Am J Respir Cell Mol Biol 1997; 17:326-33.
71.Farhat AA, Mohamad AS, Mohamad MS, et. al. AsThma remodeling: The paThogenic role of matrix metalloproteinase-9. Egypt J Chest Dis Tuberc 2014; 63:755-759.
72.Makinde T, Murphy RF, Agrawal DK. The regulatory role of TGF-beta in airway remodeling in asThma. Immunol Cell Biol 2007; 85:34856.
73.Levi-Schaffer F, Garbuzenko E, Rubin A, Reich R, Pickholz D, Gillery P, et al. Human eosinophils regulate human lung- and skin-derived fibroblast properties in vitro: a role for transforming growTh factor beta (TGF-beta). Proc Natl Acad Sci U S A 1999; 96:96605.
74. Minshall E, Chakir J, Laviolette M, Molet S, Zhu Z, Olivenstein R, Elias JA, Hamid Q. IL-11 expression is increased in severe asThma: association wiTh epiThelial cells and eosinophils. J Allergy Clin Immunol 2000; 105:232-8.
75.Shimbara A, Christodoulopoulos P, Soussi-Gounni A et al. IL-9 and its receptor in allergic and nonallergic lung disease: increased expression in asThma. J Allergy Clin Immunol 2000; 105:108-15.
76. Gounni AS, Nutku E, Koussih L, Aris F, Louahed J, Levitt RC, Nicolaides NC, Hamid Q. IL-9 expression by human eosinophils: regulation by IL-1a and TNF-a. J Allergy Clin Immunol 2000; 106:460-6.
77. Zheng X, Knight DA, Zhou D, Weir T, Peacock C, Schellenberg RR, Bai TR. Leukaemia inhibitory factor is synThesized and released by human eosinophils and modulates activation state and chemotaxis. J Allergy Clin Immunol 1999; 104:136-44.
78. Woerly G, Roger N, Loiseau S, Dombrowicz D, Capron A, Capron M. Expression of CD28 and CD86 by human eosinophils and role in The secretion of type 1 cytokines (interleukin 2 and interferon-a): inhibition by immunoglobulin a complexes. J Exp Med 1999; 190:487-95.
79.Kay AB. Allergy and allergic diseases [ first of two parts]. N Engl J Med 1998; 338:1592-600.
80.Johansson MW, Kelly EA, Busse WW, Jarjour NN, Mosher DF. Up-regulation and activation of eosinophil integrins in blood and airway after segmental lung antigen challenge . J Immunol (2008) 180 ( 11 ):762235.
81.BarThel SR, Johansson MW, McNamee DM, Mosher DF. Roles of integrin activation in eosinophil function and The eosinophilic inflammation of asThma. J Leukoc Biol 2008;83:1-12.
82.Michail S, Mezoff E, AbernaThy F. Role of selectins in The intestinal epiThelial migration of eosinophils . Pediatr Res (2005) 58 ( 4 ):6447.
83.Xu M, Dong C. IL-25 in allergic inflammation. Immunol Rev 2017; 278:185191.
84.Wang W, Li Y, Lv Z, et al. Bronchial allergen challenge of patients wiTh atopic asThma triggers an alarmin (IL-33, TSLP, and IL-25) response in The airways epiThelium and submucosa. J Immunol 2018; 201:22212231.
85.Wong CK, Cheung PF, Ip WK, Lam CW. Interleukin-25-induced chemokines and interleukin-6 release from eosinophils is mediated by p38 mitogen-activated protein kinase, c-Jun N-terminal kinase, and nuclear factor-kappaB. Am J Respir Cell Mol Biol 2005; 33: 186-94.
86.Cheung PF, Wong CK, Ip WK, Lam CW. IL-25 regulates The expression of adhesion molecules on eosinophils: mechanism of eosinophilia in allergic inflammation. Allergy 2006;6:878-85.
87.Bianchetti L, Marini MA, Isgrò M, Bellini A., Schmidt M, Mattoli S. IL-33 promotes The migration and proliferation of circulating fibrocytes from patients wiTh allergen-exacerbated asThma. Biochem Biophys Res Commun 2012; 426:116-121.
88.Li Y, Wang W, Lv Z, Li Y, Chen Y, Huang K, Corrigan CJ, Ying S. Elevated Expression of IL-33 and TSLP in The Airways of Human AsThmatics In Vivo: A Potential Biomarker of Severe Refractory Disease. J Immunol 2018; 200:2253-2262.
89.Whetstone CE, Ranjbar M, Omer H, Cusack RP, Gauvreau GM. The Role of Airway EpiThelial Cell Alarmins in AsThma. Cells 2022; 11:1105.
90.Kaur D, Gomez E, Doe C, Berair R, Woodman L, Saunders R, Hollins F, Rose FR, Amrani Y, May R, Kearley J, Humbles A, Cohen ES, Brightling CE. IL-33 drives airway hyper-responsiveness Through IL-13-mediated mast cell: airway smooTh muscle crosstalk. Allergy 2015; 70:556-67.
91.Suzukawa M, Koketsu R, Iikura M, Nakae S, Matsumoto K, Nagase H, Saito H, Matsushima K, Ohta K, Yamamoto K, Yamaguchi M: Interleukin-33 enhances adhesion, CD11b expression and survival in human eosinophils. Lab Invest 2008;88:1245-53.
92.Chow JY, Wong CK, Cheung PF, Lam CW: Intracellular signaling mechanisms regulating The activation of human eosinophils by The novel Th2 cytokine IL-33: implications for allergic inflammation. Cell Mol Immunol 2010;7:26-34.
93.Pecaric-Petkovic T, Didichenko SA, Kaempfer S, Spiegl N, Dahinden CA: Human basophils and eosinophils are The direct target leukocytes of The novel IL-1 family member IL-33. Blood 2009;113:1526-34.
94.Schmitz J, Owyang A, Oldham E, Song Y, Murphy E, McClanahan TK, Zurawski G, Moshrefi M, Qin J, Li X, Gorman DM, Bazan JF, Kastelein RA. IL-33, an interleukin-1-like cytokine That signals via The IL-1 receptor-related protein ST2 and induces T helper type 2-associated cytokines. Immunity 2005; 23:479-90.
95.Kurowska-Stolarska M, Stolarski B, Kewin P, Murphy G, Corrigan CJ, Ying S, Pitman N, Mirchandani A, Rana B, van Rooijen N, Shepherd M, McSharry C, McInnes IB, Xu D, Liew FY. IL-33 amplifies The polarization of alternatively activated macrophages That contribute to airway inflammation. J Immunol 2009; 183:6469-77.
96.Kondo Y., T. Yoshimoto, K. Yasuda, S. Futatsugi-Yumikura, M. Morimoto, N. Hayashi, T. Hoshino, J. Fujimoto, K. Nakanishi. Administration of IL-33 induces airway hyperresponsiveness and goblet cell hyperplasia in The lungs in The absence of adaptive immune system. Int. Immunol 2008; 20:791800.
97.Stolarski B, Kurowska-Stolarska M, Kewin P, Xu D, Liew FY: IL-33 exacerbates eosinophil-mediated airway inflammation. J Immunol 2010;185:3472-80.
98.Iwasaki H., S. Mizuno, R. Mayfield, H. Shigematsu, Y. Arinobu, B. Seed, M. F. Gurish, K. Takatsu, K. Akashi. Identification of eosinophil lineage-committed progenitors in The murine bone marrow. J. Exp. Med 2005; 201:18911897.
|
Home
 Design by Walter Serralheiro Design by Walter Serralheiro
|
|
|